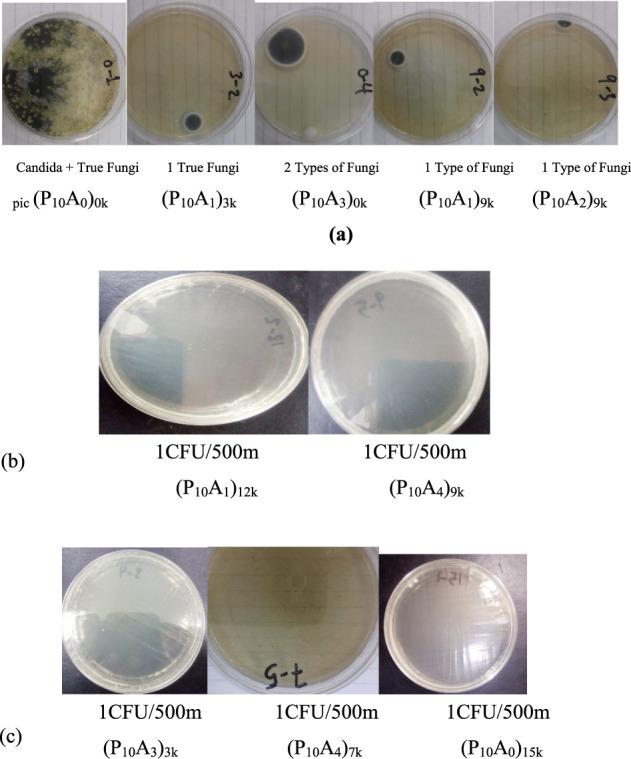
https://cdn.ncbi.nlm.nih.gov/pmc/blobs/6090/12004146/1b53faf6eaae/ao4c07119_0008.jpg

γ射线辐照合成的用于生物医学应用的含单宁酸的聚乙烯醇/抗坏血酸复合材料的增强生物粘附性和抗菌性能
Enhanced Bioadhesive and Antimicrobial Properties of PVA/Ascorbic Acid Composite with Tannic Acid Synthesized by Gamma Irradiation for Biomedical Applications.
作者信息
Adel Rashiq Shreen, Abd El-Sattar Nour E A, Abd Elhamid Hoda Abd Elhay, El-Sayyad Gharieb S, Bassioni Ghada, Ghobashy Mohamed Mohamady
机构信息
Department of Chemistry, Faculty of Science, Ain Shams University, Cairo, Abbassiya 11566, Egypt.
Basic & Medical Sciences Department, Faculty of Dentistry, Alryada University for Science & Technology, Sadat City 32897, Egypt.
出版信息
ACS Omega. 2025 Apr 3;10(14):13839-13853. doi: 10.1021/acsomega.4c07119. eCollection 2025 Apr 15.
Bioadhesive hydrogels play a crucial role in biomedical applications due to their capacity to adhere to biological surfaces. This study investigates a novel bioadhesive hydrogel system developed from poly(vinyl alcohol) (PVA) and ascorbic acid (AS), cross-linked through gamma irradiation at 7 kGy, and modified with 5 wt % tannic acid (TA). The primary objective was to enhance the hydrogel's bioadhesive, mechanical, and antimicrobial properties. Mechanical testing revealed that the (PVA/AS)/TA hydrogel exhibited significant improvements, with a lap shear strength of 92 kPa, a tensile strength of 0.57 MPa, and an elongation at break of 180%, compared to the unmodified variant. Antimicrobial efficacy was assessed against bacterial strains, including and , showing potent inhibitory effects with minimum inhibitory concentration (MIC) values of 25 μg/mL and 30 μg/mL, respectively. The findings indicate that the (PVA/AS)/TA hydrogel is a promising candidate for wound healing, drug delivery, and tissue engineering applications. It showcases its novelty in improving bioadhesive properties while providing antimicrobial functionality, thus addressing critical challenges in biomedical material design.
生物粘附水凝胶由于其粘附生物表面的能力,在生物医学应用中发挥着关键作用。本研究调查了一种新型生物粘附水凝胶系统,该系统由聚乙烯醇(PVA)和抗坏血酸(AS)制成,通过7千戈瑞的γ射线辐照交联,并以5重量%的单宁酸(TA)进行改性。主要目的是提高水凝胶的生物粘附性、机械性能和抗菌性能。机械测试表明,与未改性变体相比,(PVA/AS)/TA水凝胶有显著改善,搭接剪切强度为92千帕,拉伸强度为0.57兆帕,断裂伸长率为180%。对包括[具体菌株1]和[具体菌株2]在内的细菌菌株评估了抗菌效果,显示出强效抑制作用,最小抑菌浓度(MIC)值分别为25微克/毫升和30微克/毫升。研究结果表明,(PVA/AS)/TA水凝胶是伤口愈合、药物递送和组织工程应用的一个有前景的候选材料。它在改善生物粘附性能的同时提供抗菌功能,从而展现了其新颖性,解决了生物医学材料设计中的关键挑战。